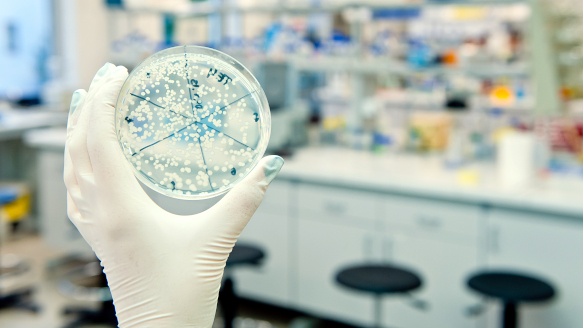
Agar plate

About Internal Medicine
As part of Chicago's oldest healthcare institution, the Department of Internal Medicine takes pride in our academic roots. We are continuously building on Rush University Medical Center's legacy, providing top-notch medical education and excellent clinical services in our 14 divisions. Our department is the academic home to more than 500 faculty, 100 fellows, 100 residents and 300+ medical students who rotate through the department. We are focused on inventing a better future for our patients, our community, and our institution.
-
Interested in joining our leadership team? Click the links below to learn more.
The Department of Internal Medicine is home to numerous robust trainee programs. Click the above link to find a list of all the educational programs that are available.
The Department of Internal Medicine has created a highly collaborative environment and infrastructure for basic science and clinical research. Click the above link to learn more.
Interested in finding a provider? Click the link above to search the Rush database.
1717 W. Congress Parkway,
10th Floor - Kellogg Building
Chicago, IL 60612
Divisions of Internal Medicine
Please contact Rush University Medical Center at (888) 352-7874
Phone: 312-942-4120
Email: DOIMadmin@rush.edu